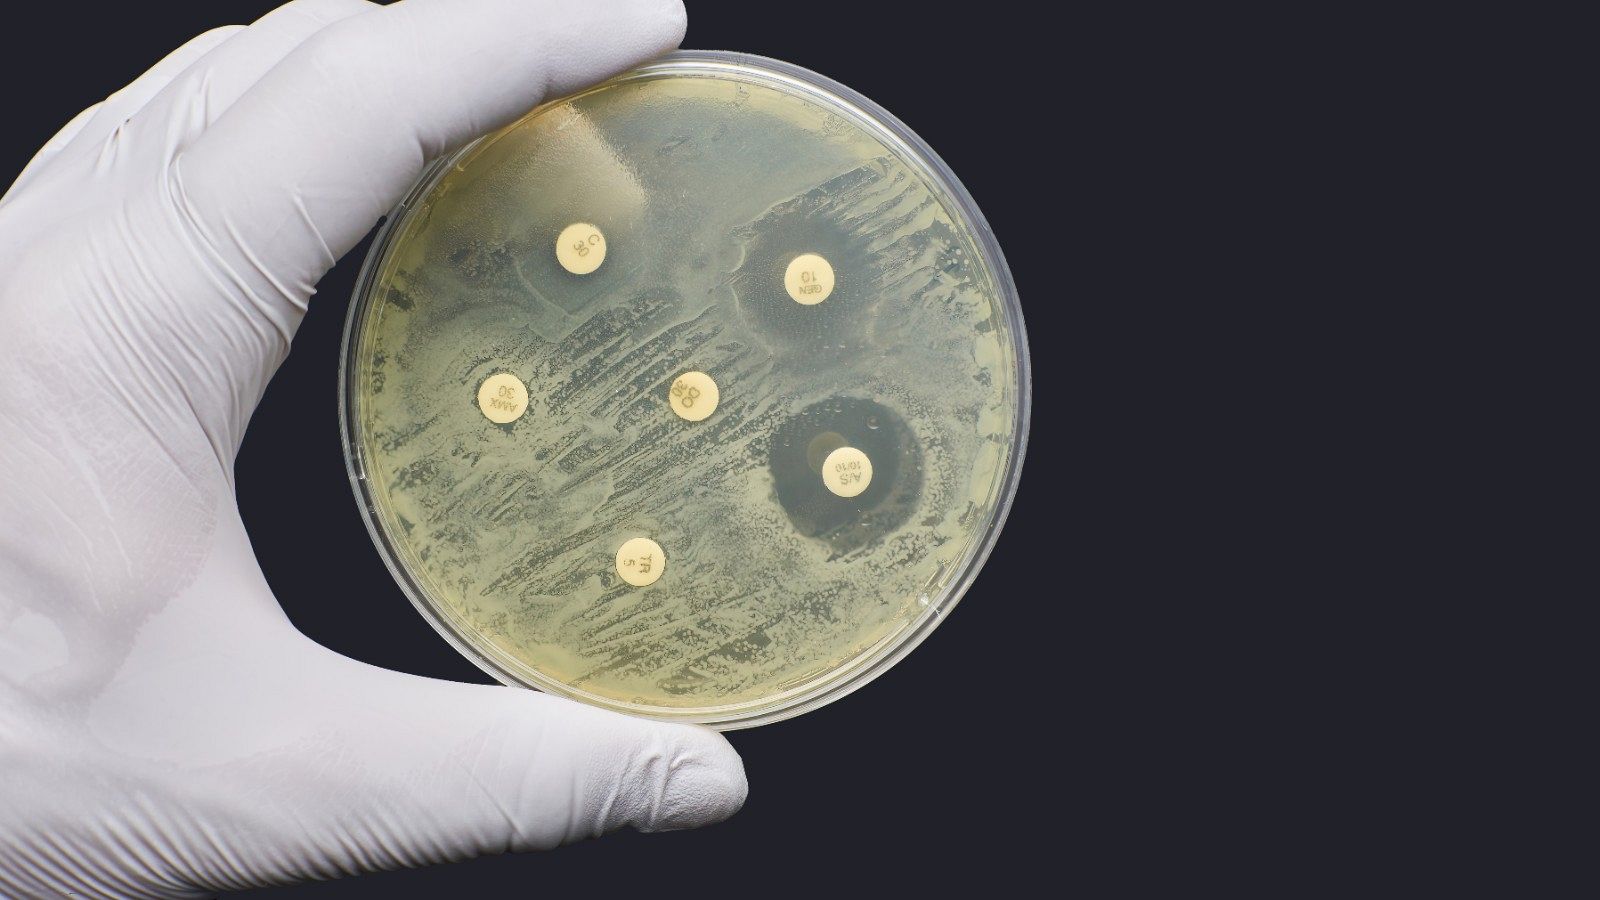
Una prueba de resistencia a los antibióticos, en una imagen de archivo

Una terapia con virus cura a un hombre de la infección de una bacteria resistente a los antibióticos
- Esta "prometedora" terapia aprovecha la naturaleza de los virus bacteriófagos para "matar" a las superbacterias
- Los investigadores estadounidenses han administrado los fagos después de una cirugía cutánea y junto con antibióticos

Un hombre de 56 años ha superado en Boston, Estados Unidos, una infección crónica en la piel causada por una bacteria resistente a los antibióticos tras recibir un tratamiento con virus bacteriófagos, según un artículo publicado en la revista Nature.
Esta "prometedora" terapia aprovecha la naturaleza de fagos para "matar" a las superbacterias, que causan ya más muertes al año en el mundo que el sida o la malaria. En este caso se ha administrado después de una cirugía cutánea y junto con antibióticos.
Es la primera vez que la terapia con fagos habría conseguido eliminar a la bacteria Mycobacterium chelonae y la primera vez que se lleva a cabo con éxito con un solo fago, destaca el artículo firmado por Jessica S. Little, del departamento de enfermedades infecciosas del Hospital Brigham and Women's y Rebekah M. Dedrick, del departamento de Biología de la Universidad de Pittsburgh.
En el proceso, “el paciente desarrolló anticuerpos neutralizantes contra el bacteriófago, pero sigue teniendo una mejora estable de la enfermedad con biopsias negativas y sin evidencia de resistencia bacteriana al fago”.
Por todo ello, las investigadoras llaman a continuar con los estudios para conocer más sobre los fagos y su potencial frente a las superbacterias.
Éxito del tratamiento junto a los antibióticos
La salud del paciente de Boston empeoró en los últimos meses de 2020 y el comienzo de 2021, con nuevas lesiones cutáneas en el brazo izquierdo, así como perdida de peso, sudores, dolor muscular y fatiga. Estaba diagnosticado además de una artritis seronegativa, una enfermedad reumatológica que le había llevado a necesitar un tratamiento inmunológico.
Los antibióticos no estaban logrando terminar con la infección y, de hecho, creaban más problemas. Primero, porque el uso prolongado de estos fármacos estaba intoxicando al paciente y, además, se estaba ahondando en la resistencia de las superbacterias.
El 10 de junio de 2021 se sometió a una segunda cirugía para tratar de reducir las lesiones cutáneas más grandes y, cinco días después, se inició la terapia con virus bacteriófagos. Se inyectaba por vía intravenosa dos veces al día junto a los antibióticos que habían formado parte de su terapia hasta el momento.
Sin apenas efectos adversos durante el proceso y con una analítica estable, el paciente recibió el alta hospitalaria el 18 de junio. "Sus lesiones cutáneas mejoraron significativamente durante las dos primeras semanas de tratamiento y continuaron mostrando una mejora constante durante los meses siguientes", detallan los especialistas.
Pese a la “excelente respuesta clínica” en este paciente, todavía quedan muchas incógnitas por despejar en cuanto a la dosis, seguridad y funcionamiento de la terapia de fagos. Uno de los obstáculos es la "alta especificidad" de estos virus, puesto que cada bacteria es susceptible solo a algunos de ellos en concreto.
Para este caso, los investigadores estadounidenses aislaron la bacteria M. chelonae para buscar fagos “potencialmente terapéuticos” frente a ella. Se probaron casi 30 virus y el denominado “Muddy” fue el único capaz de infectar y matar a la bacteria en cuestión. Este fago, de hecho, sirve también frente a M. tuberculosis y se ha utilizado terapéuticamente para tratar infecciones por M. abscessus.




